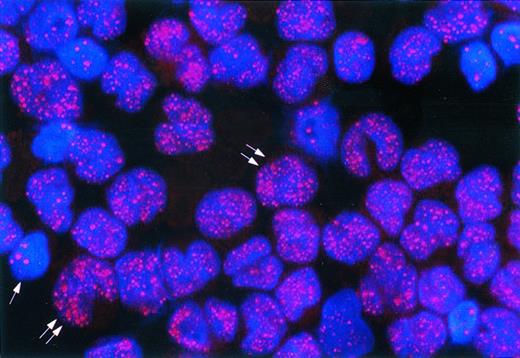
Fig. 2. APL, microgranular variant (M3V). The nuclei of APL cells (double arrows) contain many tiny dots (microgranular pattern). The single arrow points to a residual normal hematopoietic cell showing the speckled positivity of wild-type PML. Indirect immunofluorescence technique with rhodamine-labeled antibody; nuclear DAPI counterstain; original magnification × 1,000.

Abstract
Acute promyelocytic leukemia (APL) is characterized by a reciprocal 15; 17 chromosomal translocation, which fuses the promyelocytic leukemia (PML) and retinoic acid receptor α (RARα) genes, leading to the expression of the PML/RARα fusion oncoprotein. Immunocytochemical labeling of the wild-type PML protein with the PG-M3 monoclonal antibody (MoAb) directed against the amino terminal portion of the human PML gene product, produces a characteristic nuclear speckled pattern that is due to localization of the protein into discrete dots (5 to 20 per nucleus), named PML nuclear bodies. The architecture of PML nuclear bodies appears to be disrupted in APL cells that bear the t(15; 17), thus resulting in a change of the nuclear staining pattern from speckled (wild-type PML protein) to microgranular (PML-RARα fusion protein). To assess whether the PG-M3 MoAb could assist in the diagnosis of APL (M3), bone marrow and/or peripheral blood samples from 100 cases of acute nonlymphoid leukemias of different subtypes were blindly immunostained with the PG-M3 MoAb, using the immunoalkaline phosphatase (APAAP) or immunofluorescence technique as detection system. Notably, the abnormal (micropunctate) pattern of the PML/RARα fusion protein (usually ≥50 small granules/per nucleus) was observed in APL (M3) samples, but not in other types of acute nonlymphoid leukemias. Immunocytochemical labeling with PG-M3 was particularly useful in the diagnosis of microgranular variant of APL (M3V) (three cases misdiagnosed as M4 and M5), and also to exclude a morphologic misdiagnosis of APL (six of 78 cases). In all cases investigated, immunocytochemical results were in agreement with those of reverse transcription-polymerase chain reaction (RT-PCR) for PML/RARα. Because the epitope identified by PG-M3 is located in the aminoterminal portion of PML (AA 37 to 51), the antibody was suitable for recognizing APL cases characterized by breakpoint occurring at different sites of PML (bcr 1, bcr 2 and bcr 3). In conclusion, immunocytochemical labeling with PG-M3 represents a rapid, sensitive, and highly-specific test for the diagnosis of APL that bears the t(15; 17). This should allow an easy and correct diagnosis of this subtype of acute leukemia to any laboratory provided with a minimal equipment for immunocytochemistry work.
ACUTE PROMYELOCYTIC leukemia (APL) is characterized by the reciprocal 15; 17 chromosomal translocation, which fuses the promyelocytic leukemia (PML) and retinoic acid receptor α (RARα) genes.1,2 The PML breakpoints in APL can occur in three different sites: intron 6 (bcr 1 or long form), exon 6 (bcr 2 or variable form), and intron 3 (bcr 3 or short form). The most frequent sites are bcr 1 and bcr 3, bcr 2 being observed in only 10% to 15% of cases.2 The result of the translocation is the generation of a novel PML/RARα fusion protein that is thought to play a key role in the pathogenesis of APL, possibly interfering with the endogenous signalling pathways of both PML and RARα.3-6
We and others7-11 have provided evidence that the wild-type PML protein is located within the nucleus where it displays a typical speckled staining pattern due to localization of the protein into discrete, large dots (5 to 20 per nucleus), that had been previously recognized as ND1012 at immunocytochemistry and named nuclear bodies at electron microscopy.13 The PML nuclear bodies are multimolecular complexes of unknown function that, in addition to PML, contain other recently characterized proteins (Sp100, NPD52, PIC 1, Int-6).8-10,14-16 The architecture of these nuclear domains is disrupted in APL cells bearing the t(15; 17), resulting in the loss of the speckled pattern (typical of wild-type PML) and its substitution with many, small nuclear dots (microgranular positivity), where PML/RARα and PML proteins appear to colocalize.8-10 Delocalization of PML in APL cells is probably the result of PML/RARα-PML heterodimer formation.17 Notably, the microgranular positivity typical of the APL phenotype can be reversed into the wild-type speckled pattern following treatment of APL cells with all-trans–retinoic acid (ATRA) that promotes differentiation of leukemic blasts into normal cells.7-10
Several investigators7 18 have previously shown that APL can be rapidly and accurately diagnosed by immunohistochemical localization of the PML/RARα fusion protein (characterized by microgranular positivity). These studies were performed using polyclonal anti-PML antibodies that are prone to problems of nonspecific reactivity, variations between different samples, and limited availability.
In this report, a large number of acute nonlymphoid leukemias (ANLL) were stained with the PG-M3 monoclonal antibody (MoAb), that was recently raised in our laboratory against the amino terminal portion of the wild-type human PML protein.11 Aim of the study was to assess whether the immunocytochemical recognition of the abnormal microgranular pattern of the PML/RARα fusion protein using the PG-M3 MoAb could serve as a reliable test for the diagnosis of APL (M3) bearing the t(15; 17).
MATERIALS AND METHODS
The PG-M3 (anti-PML) Monoclonal Antibody
The PG-M3 MoAb was produced as previously described.11 The antibody is directed against a synthetic peptide (PSPSPTERAPASEEE) C-NH2 comprising amino acids 37 to 51 of human PML that are located in the cysteine-rich, putative DNA binding region of the protein.11 Because of its location, the epitope recognized by PG-M3 is consistently expressed by most PML isoforms and PML/RARα fusion proteins.19
Case Selection
Peripheral blood and/or bone marrow samples from 100 cases of ANLL of different subtypes were investigated for the immunocytochemical expression of the PML and PML-RARα fusion proteins. Sixty patients were studied prospectively during the period between August 1995 and October 1996. The remaining 40 cases, collected at the Institute of Hematology, University “La Sapienza,” Rome, were studied retrospectively on cytospins that had been performed at the time of initial diagnosis. Complete clinical data and morphologic diagnosis according to the French-American-British (FAB) criteria20 were available in all cases.
Ten bone marrow and 15 peripheral blood samples collected for diagnostic purposes and subsequently found to be normal were also available for study. All clinical specimens were obtained after informed consent from the patients.
Sample Processing
Peripheral blood and/or bone marrow mononuclear cells were separated by Ficoll gradient centrifugation, adjusted at the concentration of 2 × 106/mL, cytocentrifuged, air-dried at room temperature for 1 to 2 hours, and either immunostained immediately with PG-M3 (see below) or fixed in acetone for 10 minutes at room temperature and stored at −20°C until immunostaining.21 Smears were processed in the same way.
In six of 100 patients (two APL and four ANLL of M2 and M4 subtype) bone marrow biopsies were also available for study. Half of the trephine biopsy was fixed in B5 (2 hours), decalcified in EDTA, and embedded in paraffin for routine histologic examination and immunohistochemistry. The other half was snap-frozen in liquid nitrogen and cut, without decalcification, in a cryostat.22 The frozen sections (5 μm) were air-dried for 2 hours at room temperature, fixed in acetone for 10 minutes at room temperature and subjected to immunostaining.
Cell Lines
The human APL-derived cell line NB423 that bears the t(15; 17) and two well-characterized APL cases with t(15; 17) were used as positive control for the microgranular staining pattern typical of the PML/RARα fusion protein. NB4 cells were cultured in RPMI-1640 supplemented with 10% fetal bovine serum and 1% penicillin-streptomycin in a humidified CO2 incubator at 37°C. Cytospins were prepared as described above.
Immunocytochemical Labeling
Immunoalkaline phosphatase (APAAP) procedure. Smears, cytospins, and frozen sections that were to be stained immediately were fixed in acetone for 10 minutes at room temperature and then subjected to the APAAP technique, as previously described.24 Samples that had been stored at −20°C were refixed for 5 minutes in acetone at room temperature, before the immunostaining procedure.
Briefly, the samples were incubated for 30 minutes with the PG-M3 MoAb, followed by the rabbit antimouse antibody (Dako, Glostrup, Denmark) and the APAAP complexes. To increase sensitivity of the method, steps 2 and 3 were repeated ones. All steps were for 30 minutes with washes in 0.05 mol/L Tris-buffered-saline (TBS), pH 7.6. The alkaline phosphatase reaction was revealed using the new Fucsin substrate solution at the final concentration of 1 mmol/L.25 Slides were then counterstained for 5 minutes in Gill's hematoxylin and mounted in Kaiser gelatin.
Immunofluorescence labeling. Cytocentrifuge preparations were also stained in parallel by an indirect immunofluorescence technique. The cells were fixed at room temperature in methanol (5 minutes), washed in phosphate-buffered saline (PBS) and fixed in acetone (2 minutes at −20°C). As comparison, five cases were fixed in 1:1 acetone/methanol (1 minute at −10°C), as previously described by Dick et al.18 The fixed samples were incubated for 30 minutes with the PG-M3 MoAb and extensively washed in PBS containing 0.1% bovine serum albumin. The antibody binding sites were then revealed with a rhodamine- or fluorescein-conjugated antimouse antibody (Southern Biotechnology Associates, Birmingham, AL). After rinsing in PBS, the DNA was stained with DAPI (4′,6-diamidino-2-phenylindole, Sigma, St Louis, MO), made up at 1 mg/mL in PBS for 5 minutes, and rinsed again. The preparations were finally mounted in a drop of antiquenching mountant containing 1 mg/ml p-phenylendiamine in 90% glycerol, and examined on an Olympus BX-60 immunofluorescence microscope equipped with a chilled 3CCD digital color camera (C5810 Hamamatsu Photonics, Hamamatsu City, Japan). Images were captured with a 24-bit board (Image grabber 24, Neotech, London UK) on an 8100/80 Power Macintosh computer (Apple, Cupertino, CA).
Scoring of PML-RARα Expression
All APAAP- and immunofluorescence-stained samples were analyzed independently by three different observers (B.F., D.R., and L.F.) without knowledge of the clinical and morphologic diagnosis. In all cases, observers were requested to indicate exactly the nuclear staining pattern of the leukemic cells: speckled versus microgranular. A speckled pattern was defined as the presence of a limited number of discrete nuclear dots (5 to 20) not associated with nucleoli; a microgranular positivity was regarded as the presence of numerous, tiny granules (usually difficult to count) with exclusion of nucleoli.
Reverse Transcription-Polymerase Chain Reaction Studies
Reverse transcription-polymerase chain reaction (RT-PCR) studies for the presence of PML/RARα fusion transcripts in bone marrow and/or peripheral blood samples were performed in 14 leukemia cases that were found to be microgranular at immunocytochemistry, and in 51 of 78 leukemic samples with speckled PML positivity in which material was available for study.
Analysis of the isolated mRNA by RT-PCR technique was performed as previously described.26
RESULTS
PML Distribution in Normal Hemopoietic Cells
The distribution pattern of the wild-type PML protein in normal bone marrow and peripheral blood cells is shown in Table 1. In the bone marrow, erythroid cells showed low or absent expression of PML. The nuclei of megakaryocytes usually contained only a few PML positive dots. The highest amount of PML was found in myeloid elements, especially promyelocytes and myelocytes. This was confirmed by combining APAAP labeling of PML with myeloperoxidase or Sudan Black cytochemistry (data not shown). The nuclei of these cells showed the typical speckled positivity of wild-type PML, eg, the presence of 5 to 20 dots, not associated with nucleoli; no significant PML positivity was observed in the cytoplasm. There was no difference in the staining pattern of cells detected by the APAAP or indirect immunofluorescence procedures.
We also analyzed a number of hematopoietic cell lines (KG1, HL-60, U937, K562, THP1, AML1) to determine whether a correlation between stage of differentiation and level of PML expression existed. Cells were studied by indirect immunofluorescence using the anti-PML PGM3 MoAb. No correlation was found between levels of expression and differentiation status. In addition, we did not observe any correlation between in vivo and in vitro data. For example, while normal promyelocytes expressed the highest levels of PML protein and normal erythroid precursors did not express PML, the myeloblastic HL-60 and the erythroleukemic K562 cell lines expressed similar levels of PML protein. The lack of correlation between stage of differentiation and the level of expression might reflect the fact that PML is mainly involved in growth/survival regulation and that those cell lines greatly differ in their growth/survival potential.
PML Distribution in Leukemic Samples
Analysis of smears and cytospins. In general, the APAAP and immunofluorescence techniques gave similar results in cytospin preparations. Our fixation method for immunofluorescence was comparable to that previously described by Dick et al.18 The APAAP procedure was more suitable than immunofluorescence for labeling peripheral blood and bone marrow smears.
One hundred cases were immunostained with the PG-M3 MoAb. Eight of the 40 cases investigated retrospectively did not show any nuclear reactivity of the leukemic cells with PG-M3 and were regarded as nonevaluable. We interpret this finding as a false negative result, which is most likely due to the diffusion of the antigen out of the cells. This problem was mainly observed in cytospins that had been stored at −20°C for several months. The remaining 92 cases were suitable for study because PG-M3 produced optimal immunocytochemical labeling.
Seventy-eight leukemia samples showed the speckled pattern (5 to 20 dots/per nucleus) typical of the PML wild-type protein (Table 2). Seventy-two of these cases were morphologically diagnosed as ANLL of non-APL type and the remaining six as APL.
In 14 cases, the nuclei of blast cells showed the micropunctate PML positivity with consistent exclusion of nucleoli, that is typical of APL cells (Table 2; Fig 1A, B, D, E, and F; Fig 2); APL cells did not show cytoplasmic positivity for PG-M3. The nuclear dots were usually very small and frequently so numerous that they were difficult to count (Fig 1B, E, F; Fig 2). This contrasted with the limited number of discrete and larger nuclear dots (reflecting the labeling of wild-type PML protein) seen in residual hemopoietic cells (Fig 1B and Fig 2) or in cases of acute leukemias other than APL (Fig 1C and G). The positivity of the nuclei of APL cells was often so intense to be immediately recognized even at low magnification by the APAAP technique. This clearly differed from that of non-APL leukemia samples, where the wild-type speckled pattern usually required higher magnification to be visualized. In all leukemia samples investigated, the nuclear reactivity with PG-M3 was blocked when the antibody was preincubated overnight with the specific PML peptide used as immunogen.
(A) May-Grunwald-Giemsa stained cytospin of APL microgranular variant (Table 3, case 10). Notice the blast cells with markedly lobulated and invaginated nuclei (double arrows). The cytoplasm of APL cells contains no clearly recognizable granules (original magnification × 800). The single arrows indicate normal lymphoid elements. (B) Immunolabeling of the same case with the PG-M3 MoAb shows a microgranular distribution of the PML/RARα protein within the nuclei of APL cells (double arrows). This pattern contrasts with the nuclear speckled positivity (PML wild-type) of normal residual hemopoietic elements (single arrows) (indirect immunofluorescence with rhodamine-labeled antibody; nuclear DAPI counterstain; original magnification × 1,000). (C) Acute nonlymphoid leukemia of M4 subtype. Notice the typical speckled positivity (PML wild type) of blast cells (indirect immunofluorescence with fluorescein-labeled antibody; nuclear DAPI counterstain; original magnification × 1,000). (D) Peripheral blood smear of APL microgranular variant (Table 3, case 11) showing hypogranulated blasts with marked nuclear folding (arrow) (May-Grunwald-Giemsa; original magnification × 800). (E and F) The nuclei of APL cells from the same case as Fig 1D show the typical micropunctate positivity of the PML/RARα fusion protein (APAAP technique; hematoxylin counterstain; original magnifications: [E] × 800; [F ] × 1,000). (G) Acute nonlymphoid leukemia of M5 subtype. The leukemic cells display the typical speckled positivity of wild-type PML (APAAP technique; hematoxylin counterstain; original magnification × 1,000).
(A) May-Grunwald-Giemsa stained cytospin of APL microgranular variant (Table 3, case 10). Notice the blast cells with markedly lobulated and invaginated nuclei (double arrows). The cytoplasm of APL cells contains no clearly recognizable granules (original magnification × 800). The single arrows indicate normal lymphoid elements. (B) Immunolabeling of the same case with the PG-M3 MoAb shows a microgranular distribution of the PML/RARα protein within the nuclei of APL cells (double arrows). This pattern contrasts with the nuclear speckled positivity (PML wild-type) of normal residual hemopoietic elements (single arrows) (indirect immunofluorescence with rhodamine-labeled antibody; nuclear DAPI counterstain; original magnification × 1,000). (C) Acute nonlymphoid leukemia of M4 subtype. Notice the typical speckled positivity (PML wild type) of blast cells (indirect immunofluorescence with fluorescein-labeled antibody; nuclear DAPI counterstain; original magnification × 1,000). (D) Peripheral blood smear of APL microgranular variant (Table 3, case 11) showing hypogranulated blasts with marked nuclear folding (arrow) (May-Grunwald-Giemsa; original magnification × 800). (E and F) The nuclei of APL cells from the same case as Fig 1D show the typical micropunctate positivity of the PML/RARα fusion protein (APAAP technique; hematoxylin counterstain; original magnifications: [E] × 800; [F ] × 1,000). (G) Acute nonlymphoid leukemia of M5 subtype. The leukemic cells display the typical speckled positivity of wild-type PML (APAAP technique; hematoxylin counterstain; original magnification × 1,000).
APL, microgranular variant (M3V). The nuclei of APL cells (double arrows) contain many tiny dots (microgranular pattern). The single arrow points to a residual normal hematopoietic cell showing the speckled positivity of wild-type PML. Indirect immunofluorescence technique with rhodamine-labeled antibody; nuclear DAPI counterstain; original magnification × 1,000.
APL, microgranular variant (M3V). The nuclei of APL cells (double arrows) contain many tiny dots (microgranular pattern). The single arrow points to a residual normal hematopoietic cell showing the speckled positivity of wild-type PML. Indirect immunofluorescence technique with rhodamine-labeled antibody; nuclear DAPI counterstain; original magnification × 1,000.
Notably, immunocytochemical labeling with the PG-M3 MoAb allowed diagnosis of APL cases characterized by breakpoints occurring at different sites of the PML protein (Table 3).
Overall, immunocytochemistry was of great diagnostic impact because it allowed us to diagnose three cases of APL of microgranular variant (M3V) (Fig 1A and D and Fig 2) that were initially misdiagnosed as ANLL of M4 and M5 subtype on morphologic examination alone (Table 2), and also to exclude a diagnosis of APL in six cases of ANLL that were misdiagnosed as APL on morphologic and clinical basis alone (Table 2).
Analysis of bone marrow biopsies. PG-M3 labeling of frozen sections from undecalcified trephine biopsies produced results comparable to those observed in smears and cytospins, eg, speckled positivity in the four non-APL samples and microgranular positivity in the two APL cases. However, this difference in the staining pattern was abolished in paraffin sections, where both APL and non-APL cases showed a diffuse nuclear positivity for PG-M3. This clearly represents an artifact related to the fixation decalcification and/or embedding procedures.
Guidelines for the Interpretation of Immunocytochemical Staining
Because the test is based on the recognition of a different staining pattern (speckled v microgranular) rather than a positive versus negative result, the interpretation of the immunocytological labeling should not be regarded as a trivial matter. Thus, to avoid any misinterpretation of immunocytochemistry and consequent diagnostic mistakes, one should become familiar with the speckled and microgranular patterns by looking at appropriate control samples. The finding of a typical microgranular positivity ensures the correct diagnosis of APL, making molecular tests optional (eg, definition of the breakpoint region). When difficulties are encountered to assign a case of morphologically suspicious APL to the microgranular or speckled category (usually due to the suboptimal quality of cytospins and/or smears), a new sample should be obtained and the immunocytochemical studies repeated, possibly in combination with RT-PCR analysis.
RT-PCR Studies
RT-PCR studies confirmed the presence of PML-RARα fusion transcripts characteristic of the t(15; 17) in all 14 cases showing microgranular reactivity with the PG-M3 MoAb (Table 2). In contrast, RT-PCR gave negative results in 51 of the 78 leukemic samples with PML speckled positivity, available for study.
DISCUSSION
Morphologic and cytochemical criteria for diagnosing APL (M3) were established several years ago by the FAB Group.20 Immunophenotyping has been used to further increase the diagnostic accuracy of APL. The predominant immunocytological staining pattern of APL includes expression of CD13, CD15, CD33, CD38, CD45dim, and the absence of HLA-DR. While HLA-DR expression makes a diagnosis of APL unlikely, absence of HLA-DR expression is not sufficient to diagnose APL. In a control group of 306 ANLL patients, 76 (25%) lacked HLA-DR expression, but only 42 of these cases (55%) were APL.27 Expression of the CD2 molecule has been found in association with the M3 microgranular variant,28 but in a recent study on 75 APL patients, such an antigen was detected in only 9% of cases.27 Thus, at the present time, the presence or absence of antigen expression in an individual patient fails to discriminate APL from other types of ANLL.
In this report, we provide evidence that APL bearing the t(15; 17) can be confidently and rapidly diagnosed using a highly specific immunocytochemical test that is based on the recognition of the typical microgranular positivity of PML-RARα fusion protein created by the translocation, with the anti-PML MoAb PG-M3.11 The test is applicable to smears, cytospins, and frozen sections, but not to routinely fixed/decalcified, paraffin-embedded bone marrow biopsies, where the speckled pattern of the wild-type PML is artefactually changed into a microgranular or diffuse pattern.29 Notably, we found a perfect correlation between the presence of the abnormal microgranular pattern at immunocytochemistry and that of PML/RARα fusion transcripts by RT-PCR in all APL samples investigated at the time of initial diagnosis. In contrast, all non-APL leukemias were characterized by speckled (wild-type) positivity for PML and absence of PML/RARα transcripts. These results confirm and extend those previously reported by other investigators7 18 using anti-PML polyclonal antibodies.
The PG-M3 MoAb is directed against an epitope of the amino terminal part of human PML (amino acids 36-51), which is shared by most wild-type PML isoforms and PML-RARα fusion proteins.11 This allowed cases of APL with breakpoints occurring at different sites of PML (bcr 1, bcr 2 and bcr 3), to be recognized in this study. Thus, in diagnostic terms, PG-M3 appears to be superior to the anti-PML MoAb 5E1030 whose epitope (between amino acids 448 and 466) is lost in some of the PML-RARα forms (eg, bcr 3).10 Based on the frequency of breakpoint at region 3 in APL, one would then predict the inability of 5E10 to detect 40% to 50% of APL cases,2 at least in non-Latino patients.31 This applies especially to the microgranular variant (M3V) of APL that has been associated with a high frequency of bcr 3.28 Thus, at the present time, PG-M3 can be regarded as the most suitable reagent for the immunocytochemical diagnosis of APL bearing the t(15; 17).
Obviously, the PG-M3 MoAb (and any other anti-PML antibody) cannot be used to detect the t(11; 17) and t(5; 17) variants of APL that involve the formation of fusion genes (and their products) between RARα and genes other than PML (eg, promyelocytic zinc finger [PLZF] and nucleophosmin [NPM]).32 33 However, this does not detract value from the method, as the above variants are exceedingly rare (1 of 250 APL cases collected at the GIMEMA, Gruppo Italiano Malattie Ematologiche Maligne dell' Adulto) (Lo Coco F., unpublished results). Moreover, missing the diagnosis of these cases would not have clinical consequences, as they are not usually responsive to ATRA treatment.
French investigators claimed that in APL cells, the PML/RARα fusion protein, as detected by APAAP immunocytochemistry, is predominantly cytoplasmic.7,10 This led to the hypothesis that the aberrant cytoplasmic location of PML/RARα fusion protein may cause sequestration of retinoid X receptor (RXRS) in the cytoplasm with consequent impairment of the function of the nuclear receptors that require RXRS for DNA binding.10
Our finding that the PML and PML/RARα fusion proteins are consistently located within the nucleus of APL cells does not support a role for cytoplasmic location of PML/RARα in the leukemogenesis of APL.7 Similar results have been recently reported by Dick et al.18 The different immunocytochemical findings in previous studies7 10 might reflect nonspecific cytoplasmic labeling by polyclonal anti-PML antibodies and/or artefactual leakage of the protein from the nucleus to the cytoplasm.
Because of its high specificity, simplicity, rapidity, and low cost, APAAP or immunofluorescence labeling of smears and/or cytospins with the PG-M3 MoAb could well become the first choice test for diagnosis of APL, especially in developing countries where there is no availability for highly specialized tests, such as RT-PCR. Immunocytochemistry may prove useful to quickly confirm the morphologic diagnosis of APL in the typical (hypergranular) cases and to recognize the microgranular variant of APL (M3V),20 which is sometimes difficult to distinguish from acute myelomonocytic leukemia (M4) or monocytic leukemia with differentiation (M5b).34 Such a differential diagnosis is of critical importance because APL is currently treated with ATRA-containing regimens1,35 36 that markedly differ from those employed in other types of ANLL. The rapidity of the test is also of obvious clinical value when dealing with a condition such as APL that, due to the frequent hemorrhagic complications, often necessitates a prompt diagnosis and treatment.
Thus, we propose that in the future the MoAb PG-M3 should be included in the panel of reagents routinely used for the immunophenotyping of ANLL. When necessary, molecular studies should be used to further confirm the diagnosis.
The PG-M3 MoAb may also prove to be a valid adjunct to the classical FAB criteria for epidemiological studies aiming to assess the frequency of APL among ANLL. In fact, recent reports strongly suggest that APL may be particularly frequent among certain ethnic groups, eg, Latinos both in the United States37 and South America.38
Although, we did not systematically investigate the value of the MoAb PG-M3 for the assessment of minimal residual disease, the positive results reported in a previous study with polyclonal anti-PML antibodies18 would suggest that PG-M3 may be suitable for this purpose as well. A study is presently ongoing to address this point in a large number of APL patients enrolled in the GIMEMA.
ACKNOWLEDGMENT
Dr Michael Lanotte generously provided the NB4 cell line employed in this study. We thank Roberta Pacini, Laura Natali Tanci, and Barbara Bigerna for the excellent technical assistance, and Claudia Tibidò for the secretarial assistance.
Supported by AIRC (Associazione Italiana Ricerca Cancro) Milan, Italy and CNR (progetto finalizzato 4 ACRO) Italy.
Address reprint requests to Brunangelo Falini, MD, Istituto di Ematologia, Policlinico, Monteluce, 06100 Perugia, Italy.

![Fig. 1. (A) May-Grunwald-Giemsa stained cytospin of APL microgranular variant (Table 3, case 10). Notice the blast cells with markedly lobulated and invaginated nuclei (double arrows). The cytoplasm of APL cells contains no clearly recognizable granules (original magnification × 800). The single arrows indicate normal lymphoid elements. (B) Immunolabeling of the same case with the PG-M3 MoAb shows a microgranular distribution of the PML/RARα protein within the nuclei of APL cells (double arrows). This pattern contrasts with the nuclear speckled positivity (PML wild-type) of normal residual hemopoietic elements (single arrows) (indirect immunofluorescence with rhodamine-labeled antibody; nuclear DAPI counterstain; original magnification × 1,000). (C) Acute nonlymphoid leukemia of M4 subtype. Notice the typical speckled positivity (PML wild type) of blast cells (indirect immunofluorescence with fluorescein-labeled antibody; nuclear DAPI counterstain; original magnification × 1,000). (D) Peripheral blood smear of APL microgranular variant (Table 3, case 11) showing hypogranulated blasts with marked nuclear folding (arrow) (May-Grunwald-Giemsa; original magnification × 800). (E and F) The nuclei of APL cells from the same case as Fig 1D show the typical micropunctate positivity of the PML/RARα fusion protein (APAAP technique; hematoxylin counterstain; original magnifications: [E] × 800; [F ] × 1,000). (G) Acute nonlymphoid leukemia of M5 subtype. The leukemic cells display the typical speckled positivity of wild-type PML (APAAP technique; hematoxylin counterstain; original magnification × 1,000).](https://ash.silverchair-cdn.com/ash/content_public/journal/blood/90/10/10.1182_blood.v90.10.4046/3/m_bl_0044f1.jpeg?Expires=1770307231&Signature=hMOmM4~KZbj999hkUHncamOeIvUvJHe-sJzJiPZGvsrb5i8A6V8NppQLEi6KzVES-SO8eUVol8Ih-kQh7RoLxFl7sM-Lfsbi1IrHirH5Bj~ywr8AltEjlax-KUpP78vHHXVxcoPG7SUyxZAcXdudez8FKCMZQuxA1QcXcVGnb9W8Jf42FOjQqbJDu7qkUMZ0KRCyP8az8jx9rRn63vltzVcE-ETyPUTaFXGigMmvvpG0vsV0TCvo0wXy5x-8C8VI4~FShLe-fLVofyq4H7IaWmWzpTbgTAKxD-rDtcHbDGLSnWMa4wrbGeaucP3Dn5p~zhIvIPncac8TfyXxnqesLQ__&Key-Pair-Id=APKAIE5G5CRDK6RD3PGA)


![Fig. 1. (A) May-Grunwald-Giemsa stained cytospin of APL microgranular variant (Table 3, case 10). Notice the blast cells with markedly lobulated and invaginated nuclei (double arrows). The cytoplasm of APL cells contains no clearly recognizable granules (original magnification × 800). The single arrows indicate normal lymphoid elements. (B) Immunolabeling of the same case with the PG-M3 MoAb shows a microgranular distribution of the PML/RARα protein within the nuclei of APL cells (double arrows). This pattern contrasts with the nuclear speckled positivity (PML wild-type) of normal residual hemopoietic elements (single arrows) (indirect immunofluorescence with rhodamine-labeled antibody; nuclear DAPI counterstain; original magnification × 1,000). (C) Acute nonlymphoid leukemia of M4 subtype. Notice the typical speckled positivity (PML wild type) of blast cells (indirect immunofluorescence with fluorescein-labeled antibody; nuclear DAPI counterstain; original magnification × 1,000). (D) Peripheral blood smear of APL microgranular variant (Table 3, case 11) showing hypogranulated blasts with marked nuclear folding (arrow) (May-Grunwald-Giemsa; original magnification × 800). (E and F) The nuclei of APL cells from the same case as Fig 1D show the typical micropunctate positivity of the PML/RARα fusion protein (APAAP technique; hematoxylin counterstain; original magnifications: [E] × 800; [F ] × 1,000). (G) Acute nonlymphoid leukemia of M5 subtype. The leukemic cells display the typical speckled positivity of wild-type PML (APAAP technique; hematoxylin counterstain; original magnification × 1,000).](https://ash.silverchair-cdn.com/ash/content_public/journal/blood/90/10/10.1182_blood.v90.10.4046/3/m_bl_0044f1.jpeg?Expires=1770307232&Signature=g1eo6VDcmQWWQLZhwo4K2FNrOcEbNhrZyqwVmiXOXwqZQLsITYfVmcwgw~sXSs4j6apNMOoPX1XemKKGN3CkEh5i9zPA8mFK~xnZgcNd-FcHXyEVFiBpxWfOE4gt8m~21BhB-7b2nzJjqLvyQJuLr5fuyFkfJlmgeZ~YXvTLOH8NQwlyJxypN48hMOTdkbP5SrDpxz7i6C4LqzBAx1rFT7v0clcT2Qu95COxChd-tWkGCd1159e-Wq4hsNIa0MISBoYhHOPmdRGnAIl7P5stkV9XwbrFVv8-6QNvY9n201INVoob35Wsl-wjUXw6elU2cgJq5Q~d~9KEAsua-YbIKw__&Key-Pair-Id=APKAIE5G5CRDK6RD3PGA)